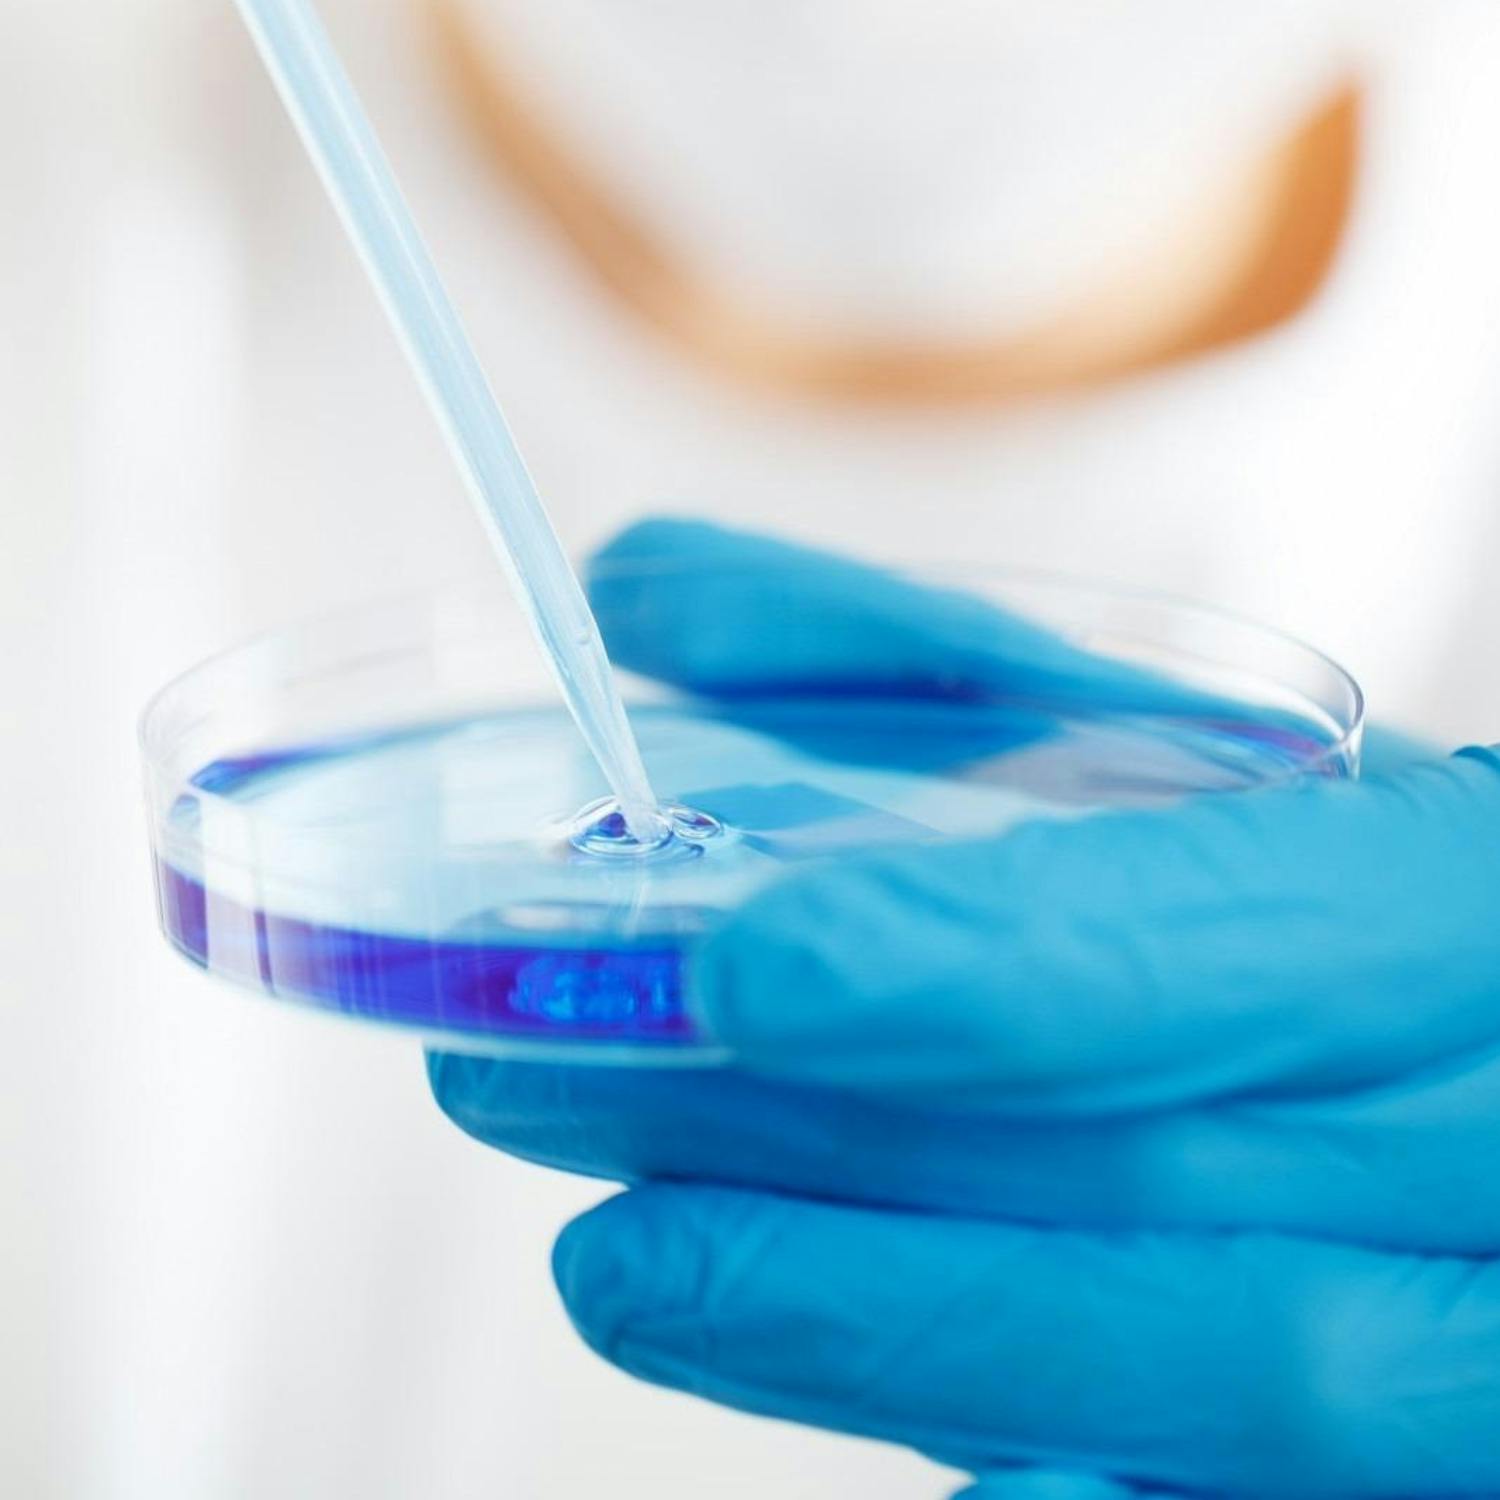

Every Wednesday afternoon, we’ll be talking Making Babies.
Andrea will be joined by Professor Shane Higgins, Master of the National Maternity Hospital to cover every area of trying to have a baby. From the very start of knowing how to prepare, right up to pregnancy – and all the bumps in the road in between.
This week, Shane joins Andrea to discuss what seems to be a new medical breakthrough, and answer your questions.
Comments (3)
More Episodes
All Episodes>>Create Your Podcast In Minutes
- Full-featured podcast site
- Unlimited storage and bandwidth
- Comprehensive podcast stats
- Distribute to Apple Podcasts, Spotify, and more
- Make money with your podcast
It is Free











